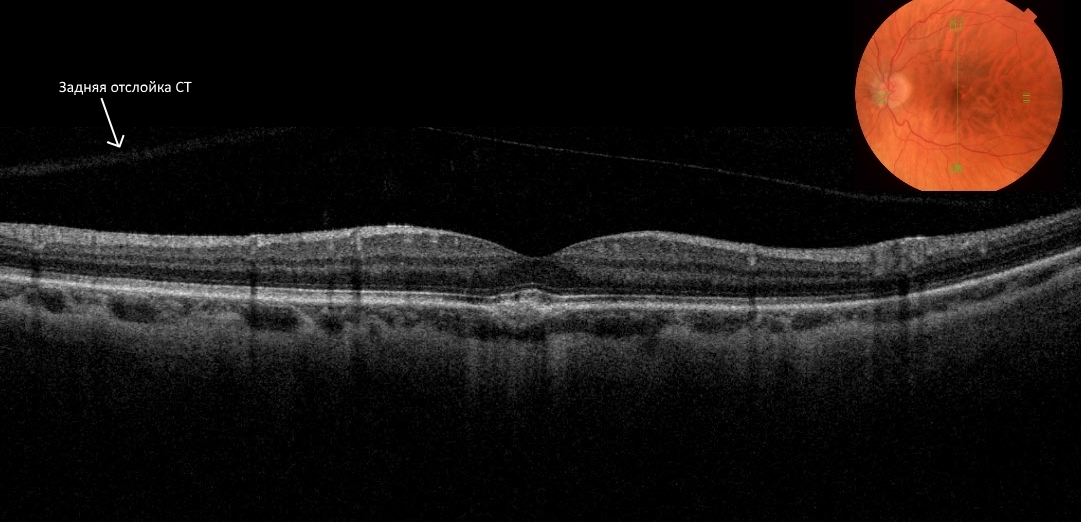
ЗОСТ

Классификация
Существует ряд классификаций отслойки ЗГМ, авторы которых руководствовались либо особенностями морфологии, либо различиями в патогенезе. Согласно распространенной классификации Hruby различают следующие виды задней отслойки СТ.
- Полная задняя отслойка: простая отслойка; отслойка с коллапсом структур СТ; воронкообразная отслойка; атипичная отслойка.
- Частичная задняя отслойка: верхняя, задняя, боковая или нижняя отслойка; атипичная отслойка.
При простой полной задней отслойке СТ сжимается, но его задняя поверхность сохраняет сферическую форму. Следствием отслойки является отделение СТ от ДЗН с формированием препапиллярного пространства, а также возможно помутнение витреума. Простая отслойка встречается обычно в молодом возрасте, когда гель СТ имеет более оформленную структуру, участки разжижения (синерезиса) отсутствуют, а отделяемая глиальная мембрана непрерывна и прозрачна, что затрудняет диагностику данного состояния. Только в случае уплотнения кортикального слоя СТ можно увидеть заднюю поверхность СТ. Колебательные движения гиалоида, столь характерные для отслойки СТ с коллапсом, отсутствуют.
Полную простую заднюю отслойку следует отличать от (1) мембранных образований в пределах СТ связанных с задним увеитом и геморрагиями, и (2) контурами восходящей части клокетова канала, расположенного перед ДЗН. Простая полная задняя отслойка СТ может быть результатом проникновения экссудата из хориоретинального очага, геморрагий между СТ и сетчаткой или ретракции кортикального слоя в случае наличия внутри СТ экссудата. Подобная картина обычно наблюдается при сочетании с задним увеитом, когда уплотнение кортикального слоя СТ происходит без коллапса геля. При этом на внешней поверхности отслойки заметны преципитаты и линии напряженности из-за уплотнения кортикального слоя СТ. В ретровитреальном пространстве можно обнаружить клеточные элементы СТ.
При полной задней отслойке с коллапсом СТ задняя поверхность отслоенного витреума располагается почти вертикально в плоскости его верхнего основания близко к хрусталику. При любых движениях СТ начинает совершать волнообразные движения по направлению к заднему полюсу глаза. Очень часто в препапиллярной зоне СТ на его задней поверхности обнаруживается помутнение, состоящее из глиальной ткани ДЗН, оторванной от мениска диска при отслойке. На ЗГМ также может присутствовать ткань из хориоретинальных рубцов, складок сетчатки, макулярного и других разрывов сетчатки. ЗГМ при ее отслойке с течением времени становится более уплотненной и слегка выделяется. На данный процесс есть разные точки зрения: или это связано со склонностью коллоидных растворов к уплотнению на поверхности, или вызвано клеточной пролиферацией на ЗГМ.
Воронкообразная задняя отслойка является относительно редкой формой задней отслойки СТ, при которой контакт СТ с сетчаткой остается только в области ДЗН или прилежащих к нему участках. Это может быть связано с прободными ранениями глаза или другими патологическими процессами, например с пролиферативной ретинопатией.
Атипичная полная задняя отслойка встречается в случаях остаточного контакта СТ с сетчаткой на периферии глазного дна, например в очаге хориоретинита, или после экстракции катаракты, осложненной потерей части СТ, а также после прободных ранений.
Jaffe также разделил полную отслойку ЗГМ по степени ретракции СТ на небольшую, умеренную, выраженную и крайне выраженную.
А.И. Горбань, в дополнение к классификации Jaffe, определил конкретные ориентиры для систематизации вида отслойки по степеням:
- I — ЗГМ видна только с линзой Груби;
- II — ЗГМ видна без линзы, но при максимальном приближении щелевой лампы к глазу;
- III — свободное выявление складчатой ЗГМ без линзы Груби;
- IV — ЗГМ без складок, приближена к хрусталику меньше, чем на глубину его оптического среза.
Частичная отслойка является менее распространенной, чем полная, и включает в себя следующие подвиды.
- Верхняя частичная отслойка: ЗГМ отделяется от основания СТ позади хрусталика, провисает вниз и может колебаться при движении глазного яблока. Препапиллярное помутнение отсутствует, линия прикрепления к сетчатке часто хорошо выражена. Данная отслойка первична по механизму, ее связывают с последствиями возрастных изменений СТ и, кроме того, она может способствовать развитию задней полной отслойки с коллапсом.
- Задняя частичная отслойка: ЗГМ при данной форме частично отрывается от зоны ДЗН, хотя сохраняет контакт с большей частью сетчатки. Причинами могут быть как преретинальное кровоизлияние, так и пролиферативная ретинопатия.
- Латеральная и нижняя частичные отслойки ЗГМ часто являются переходными процессами, сочетающимися с очагом хориоидита, ограниченным ретинальным перифлебитом или интраокулярным инородным телом.
- Атипичная частичная задняя отслойка ЗГМ, как и атипичная полная задняя отслойка, сочетается с хориоретинальными очагами, осложнениями катарактальной хирургии или прободными ранениями глазного яблока.
В 1997 году A. Kakehashi и соавторы, представили новую классификацию. В ней выделено 4 типа отслойки ЗГМ, каждый из которых хорошо коррелировал с определенными патологическими состояниями.
- 1 тип: полная задняя отслойка СТ, часто сочетающаяся с миопией высоких степеней без строгой корреляции с возрастом.
- 2 тип: полная задняя отслойка СТ без коллапса, которая была типичной у больных с увеитом или окклюзией центральной вены сетчатки
- 3 тип: частичная задняя отслойка СТ с утолщением задней витреальной коры, наблюдаемая у 90% больных пролиферативной диабетической ретинопатией.
- 4 тип: частичная задняя отслойка СТ без утолщения задней витреальной коры, часто ассоциирована с возрастными изменениями стекловидного тела.
E. Uchino и соавторы (2001) классифицировали заднюю отслойку СТ, используя оптическую когерентную томографию, при этом выделили 5 стадий формирования отслойки СТ:
- 0 — нет задней отслойки СТ;
- 1 — неполная перифовеолярная отслойка площадью до 3 квадрантов;
- 2 — неполная задняя отслойка СТ во всех квадрантах с сохраняющимся прикреплением СТ к сетчатке в области фовеа и ДЗН;
- 3 — неполная задняя отслойка СТ, охватывающая весь задний полюс, но с остающимся прикреплением к ДЗН;
- 4 — полная задняя витреальная отслойка
Таким образом, прослеживалась этапность развития отслойки ЗГМ: вначале СТ отслаивается от сетчатки в заднем полюсе с сохранением фиксации у ДЗН и фовеа, затем происходит отрыв от фовеа и, наконец, СТ полностью отделяется от структур заднего полюса, смещаясь кпереди.
Врачи отмечают, что задняя отслойка стекловидного тела является распространенным состоянием, особенно у людей старше 50 лет. Это связано с естественными возрастными изменениями в глазах, когда стекловидное тело теряет свою эластичность и начинает отделяться от сетчатки. Специалисты подчеркивают, что в большинстве случаев это состояние не вызывает серьезных проблем и может протекать бессимптомно. Однако важно обращать внимание на такие симптомы, как вспышки света или плавающие пятна, так как они могут указывать на более серьезные осложнения, включая разрыв сетчатки. Врачи рекомендуют регулярные осмотры у офтальмолога, особенно для людей с предрасположенностью к заболеваниям глаз. Своевременная диагностика и наблюдение позволяют избежать возможных осложнений и сохранить зрение.

Клинические проявления задней отслойки СТ
Задняя отслойка СТ с коллапсом сопровождается внезапными энтоптическими феноменами и фотопсиями (световые полосы Моора). Пациент жалуется на вспышки, молнии, блестки, сверкания, в течение некоторого времени перед внезапным началом процесса наблюдает в поле зрения нитевидные «плавающие объекты», затем появляется помутнение в виде точечных включений, мушек, паучков, в виде кольца, фигуры восьмерки, запонки и др.
Если коллапс СТ массивный, то ЗГМ, содержащая препапиллярное помутнение, приближается к хрусталику, где оно меньше беспокоит пациента. Небольшие участки помутнения бросают тень на область диска и остаются невидимыми для пациентов. Вспышки света не постоянно сопутствуют отслойке и наблюдаются чаще с височной стороны. Возникновение вспышек относят к субъективным проявлениям остаточных витреоретинальных контактов при задней отслойке СТ. Причиной служит удароподобное действие отслоенного СТ на сетчатку в момент движения глазного яблока. Продолжительность появления вспышек — от нескольких недель до месяца и более.
Некоторые пациенты при сочетании задней отслойки с геморрагиями сообщают о феномене «поднимающегося дыма». Феномен становится наиболее выраженным, если кровь собирается в ретровитреальном пространстве, а не среди витреальных фибрилл. По наблюдениям некоторых авторов, циркулярный периметр расширяющейся зоны отслойки стекловидного тела может восприниматься больными как неярко мерцающее кольцо, диаметр которого постепенно увеличивается.
Структуры СТ, влияющие на развитие ЗОСТ
Стекловидное тело является многокомпонентной и сложно устроенной структурой, но изменения, способные привести к его задней отслойке, в первую очередь, могут быть вызваны нарушением организации или функции следующих элементов СТ: пограничные слои СТ, макромолекулярный каркас, клетки, участвующие в синтезе макромолекул и поддержании гомеостаза СТ. Кортикальный слой СТ, состоящий из плотно упакованных фибрилл коллагена II типа, имеет неодинаковую толщину в различных отделах глазного дна. В некоторых местах в кортикальном слое формируются так называемые «люки», через которые при нарушении целостности пограничных слоев витреума жидкая часть стекловидного тела может проникать в ретрогиалоидное пространство, способствуя развитию отслойки ЗГМ. Наиболее часто такая картина наблюдается в препапиллярной части кортикального слоя витреума.
Внутренняя пограничная мембрана (ВПМ) сетчатки также имеет неодинаковую толщину в разных отделах глазного дна, при этом в местах наименее прочного контакта с ЗГМ ее толщина значительно больше и с возрастом увеличивается. ЗГМ соединена с внутренней пограничной мембраной сетчатки за счет фибрилл СТ, напрямую связанных с базальной мембраной клеток Мюллера. Таким образом, повреждение ВПМ значительно ослабляет ее связь с ЗГМ.
Основу макромолекулярного каркаса СТ составляют две молекулы — коллаген и гиалуроновая кислота.
- Коллаген. В стекловидном теле находится преимущественно коллаген II типа (80% всего коллагена), а в области ЗГМ и зоне витреоретинального контакта содержится коллаген IV типа. Исходя из этого отслойка ЗГМ может быть описана как разделение между коллагеном II типа кортикального слоя заднего СТ и коллагеном IV типа поверхности сетчатки. За синтез коллагена СТ отвечают мюллеровские клетки сетчатки, и при повреждении вследствие ряда причин клеточных структур сетчатки происходит нарушение обновления коллагеновых структур и деградация имеющихся фибрилл коллагена. Кроме того, в синтезе принимают участие фибробласты, и от их синтетической активности, которая с возрастом снижается, может зависеть состояние коллагенового каркаса СТ. Возникающие вследствие этого изменения витреума в литературе трактуются как возрастные.
- Гиалуроновая кислота (ГК), вторая важнейшая макромолекулярная структура СТ, является полианионом, ее конформация зависит от степени гидратации и физико-химических свойств среды. Биосинтез ГК происходит в гиалоцитах, цилиарном теле и клетках Мюллера сетчатки, субстратом для чего служит глюкоза, поступающая из экстрацеллюлярного матрикса. Содержание в кортикальном слое СТ глюкозаминогликанов с возрастом уменьшается, содержание протеинов увеличивается. Хотя считается, что уровень ГК остается постоянным благодаря истечению молекул гиалуроновой кислоты из стекловидного тела через передний сегмент глаза и, возможно, из-за поглощения ее гиалоцитами, тем не менее содержание ГК может изменяться под действием стероидных гормонов, что частично может объяснить возрастные и половые различия в содержании гиалуроновой кислоты.
Описанные макромолекулярные компоненты витреума создают каркас СТ. Гиалуроновая кислота образует запутанную губчатую молекулярную полианионную сеть, которая заполняет пространство между волокнами коллагена, организованного в трехмерную сеть беспорядочно ориентированных волокон, и оказывает «стабилизирующее влияние» на коллагеновую сеть. Фибриллы коллагена постоянно находятся на некотором расстоянии друг от друга. Такое устройство двойной сети обеспечивает как прохождение света, так и вискоэластичные и механические функции СТ.
Среди клеточных популяций СТ основной является популяция гиалоцитов, которая составляет около 80% клеток витреума. В них происходит биосинтез гиалуроновой кислоты, кроме того, они участвуют в синтезе коллагена и обладают фагоцитарной активностью. В покоящемся состоянии гиалоциты участвуют в синтезе гликозаминогликанов и гликопротеидов, при этом макромолекулы могут повторно поглощаться путем пиноцитоза и перерабатываться для новых синтетических циклов. Фагоцитарная функция активируется в ответ на медиаторы воспаления. Возможно, гиалоциты наравне с резидентными фибробластами — первые клетки, вступающие в контакт со всеми мигрирующими или митогенным стимулами.
Задняя отслойка стекловидного тела (ЗОСТ) — это состояние, о котором многие люди начинают говорить, когда сталкиваются с проблемами зрения. Часто пациенты описывают свои ощущения как появление «плавающих» точек или нитей перед глазами, что может вызывать беспокойство. Некоторые отмечают, что это состояние сопровождается вспышками света, что также вызывает страх. Однако большинство врачей подчеркивают, что ЗОСТ в большинстве случаев не является опасным и не требует лечения. Тем не менее, важно не игнорировать симптомы и обратиться к специалисту, чтобы исключить более серьезные заболевания. Люди делятся своим опытом в интернете, обсуждая, как они справлялись с этим состоянием и какие рекомендации получили от врачей. Общая рекомендация — следить за изменениями в зрении и регулярно проходить обследования, чтобы сохранить здоровье глаз.

Факторы, способствующие ЗОСТ
Возраст. Основной причиной развития задней отслойки СТ принято считать возрастные изменения в СТ. При старении в результате биохимических сдвигов развиваются фибриллярная дегенерация, оводнение и коллапс витреума. Так, более 50% ткани СТ подвергается разжижению и ликвификации у 25% людей в возрасте от 40 до 49 лет, и у 62% людей в возрасте от 80 до 89 лет. Эти процессы начинаются в более раннем возрасте, но в этот период при клиническом исследовании они не выявляются.
Кроме того, в области переднего основания СТ с возрастом слабеют клеточные барьеры и здесь становится возможным выход, например, эритроцитов из преретинального эпителия в витреум. На уровне основания СТ обнаруживаются цилиндрические полости, замкнутые мембраной в цилиарном конце и заполненные мукополисахаридами в большей концентрации, чем в других участках СТ. Данные полости являются основным местом проникновения плазматических мукополисахаридов и белков в СТ.
Аметропия. Как было указано, задняя отслойка СТ чаще развивается при миопии. Вероятность развития билатеральной отслойки с коллапсом увеличивается при миопии более 3 дптр.
Гормональная дисфункция. Наиболее высока встречаемость отслойки ЗГМ, связанной с возрастом у, женщин, что может быть вызвано гормональной дисфункцией после менопаузы, когда уровень эстрогенов, оказывающих определенное влияние на синтез гликозаминогликанов, снижается. Так, Larsen и Osterlin выявили, что в случае отслойки ЗГМ концентрация гиалуроновой кислоты в СТ у мужчин (120,89 мг/мл) выше, чем у женщин (79,53 мг/мл; p < 0,01).
Воспалительные процессы. Поскольку для очагов воспаления характерно изменение рН в кислую сторону, то в случае воспалительных процессов в области заднего отрезка глаза возможно нарушение структурной организации макромолекулярных компонентов витреума с развитием его коллапса и дальнейшей отслойкой. Отслойка ЗГМ была неоднократно описана в сочетании с хориоретинальными очагами при заднем увеите, с очагами хориоидита, с ограниченным ретинальным перифлебитом или с интраокулярным инородным телом.
Соматические заболевания. Определенное влияние на развитие задней отслойки СТ оказывает наличие сахарного диабета, при котором происходит интенсификация перекисного окисления липидов. Свободные радикалы, проникающие в область витреоретинального контакта и витреум, приводят к деградации макромолекулярного остова стекловидного тела с последующим развитием задней отслойки СТ. Патологический процесс в этом случае начинается в макулярной области, так как в ней метаболические процессы протекают наиболее интенсивно.
Травмы. В различных наблюдениях было отмечено развитие задней отслойки СТ после прободных ранений, операционных вмешательств, связанных со вскрытием глазного яблока.
Механизм развития ЗОСТ
При отслойке ЗГМ, с одной стороны, изменяются реологические свойства геля СТ, что ведет к сжижению и фракционированию, с другой — снижаются контактные свойства кортикального слоя СТ. Под воздействием ряда факторов происходят дегенеративные изменения плотной мембраны вторичного витреума, снижается количество гиалоцитов в кортикальных слоях СТ, нарушается баланс гиалуроновой кислоты, что ведет к снижению возможности связывать воду. В определенный момент, когда на фоне разжиженного СТ утрачивается структура коллагеновой сети из-за нарушения стабилизирующего влияния молекул гиалуроновой кислоты, развивается синерезис СТ.
На этой стадии развития отслойки ЗГМ кортикальный слой СТ, прилежащий к сетчатке, остается интактным, хотя и истончается, из-за чего становится возможной отслойка ЗГМ. В дальнейшем, если витреоретинальное соединение оказывается более прочным, чем внутривитреальные связи, коллабирующий гель СТ сохраняет тесный контакт с сетчаткой, располагаясь более или менее тонким слоем по внутренней поверхности стенки глазного яблока. Дефицит объема заполняется маловязкой жидкостью.
Более часто параллельно с синерезисом геля СТ происходит и ослабление витреоретинальной связи. Происходит распад пограничных мембран, расщепление кортикального коллагена или даже поверхностных слоев глии сетчатки. Формируются условия для отделения основной массы оформленного гиалоида от внутренней поверхности глазного дна на всех участках, где не существует их особо прочной связи.
В случае задней отслойки СТ с коллапсом наиболее вероятно, что у заднего полюса происходит растворение кортикального слоя СТ и выход жидкой части витреума в ретровитреальное пространство через сформировавшееся препапиллярное отверстие и премакулярный кортикальный слой СТ. Длительность процесса может быть различной — от минут до часов. Определенную роль играют движения глазного яблока, поскольку при этом жидкость в ретровитреальном пространстве действует как клин, отсепаровывая ЗГМ от подлежащей сетчатки.
Затем происходит коллапс оставшегося геля витреума; волокна смещаются кпереди, где гель провисает вниз от верхнего места фиксации у зубчатой линии. ЗГМ собирается в складки. Если проникновение жидкости в ретровитреальное пространство сочетается с процессом коллапса структур витреума, то можно ожидать формирования гладкой поверхности ЗГМ с вогнутостью вверх. Напротив, места остаточного прикрепления ЗГМ к задней стенке стекловидной полости различимы и ведут к появлению складок, которые при движениях глазного яблока остаются неподвижными.
Фибропластические процессы в кортикальном слое СТ постепенно приводят к уплотнению и сокращению ЗГМ, что также за счет тракций способствует распространению ЗОСТ вплоть до полной. Постепенное смещение ЗГМ от сетчатки к хрусталику может быть количественно оценено путем биомикроскопии. Если отделение СТ от ДЗН происходит в конце коллапса геля (на фоне «воронкообразной» отслойки СТ), то развивающееся тракционное усилие бывает достаточным для повреждения сосудов диска.

Роль ЗОСТ в витреоретинальной хирургии
Важность изучения проблемы задней отслойки СТ обусловлена той ролью, которую играет ЗГМ в патогенезе ряда заболеваний. Так, отслойка ЗГМ имеет важное патогенетическое значение при возникновении регматогенной отслойки сетчатки как фактор формирования разрыва сетчатки в области патологической фиксации СТ к участкам дистрофий сетчатки.
Идиопатические макулярные отверстия также могут возникать в процессе отслойки ЗГМ вследствие тракционного воздействия на ткань сетчатки в области макулы.
Большое значение имеет развитие полной отслойки ЗГМ при пролиферативной диабетической ретинопатии (ПДР): в случае раннего ее развития значительно уменьшается возможность возникновения витреоретинальной пролиферации и последующей тракционной отслойки сетчатки. При этом значительную роль играет также характер отслойки ЗГМ: при наступлении полной отслойки скорость и выраженность пролиферативной витреоретинопатии значительно уменьшаются, а состояние частичной отслойки ЗГМ способствует ускорению и утяжелению течения ПДР, что требует, как правило, активной витреоретинальной хирургии.
Для предупреждения данных состояний сегодня применяются медикаментозные методы индукции ранней отслойки ЗГМ. С этой целью при проведении витрэктомии используют интравитреальные инъекции протеолитических ферментов, в частности плазмина, гемазы, поливинилпирролидона.
Таким образом, задняя отслойка стекловидного тела в настоящее время рассматривается как клинически значимый полиэтиологический процесс, в котором происходит нарушение витреоретинального соединения. Несмотря на большое количество исследований, посвященных аспектам формирования и развития дегенеративных изменений стекловидного тела и его задней отслойки, ряд вопросов, связанных с влиянием на развитие отслойки ЗГМ биохимических, биомеханических, возрастных, воспалительных, аутоиммунных процессов, требует дальнейшего изучения. Кроме того, в клинической офтальмологии необходимо уделять пристальное внимание состоянию ЗГМ и СТ, стремясь к выявлению факторов дегенеративных изменений витреума и индукции отслойки ЗГМ.
Вопрос-ответ
Что такое ЗОСТ в офтальмологии?
Задняя отслойка стекловидного тела – это состояние, характеризующееся отделением задней гиалоидной мембраны от пограничной внутренней мембраны сетчатки, влекущее за собой и отделение стекловидного тела (СТ). Лечения при задней отслойке стекловидного тела (ЗОСТ) в большинстве случаев не требуется.
Является ли отслойка стекловидного тела серьезной проблемой?
Отслоение стекловидного тела иногда может привести к более серьёзным заболеваниям глаз: разрыву сетчатки. Иногда волокна стекловидного тела при отслоении прорывают сетчатку. Если не начать лечение вовремя, это может привести к отслоению сетчатки.
Что делать при отслойке стекловидного тела?
Лечение только хирургическое, проводится при наличии осложнений. Без клинических проявлений и жалоб пациента отслойка стекловидного тела не требует проведения специальных мероприятий. Развитие осложнений, таких как отслойка сетчатки, является показанием к оперативному вмешательству.
Советы
СОВЕТ №1
Регулярно проходите обследования у офтальмолога, особенно если у вас есть предрасположенность к заболеваниям глаз. Раннее выявление задней отслойки стекловидного тела может помочь предотвратить более серьезные осложнения.
СОВЕТ №2
Обратите внимание на изменения в зрении, такие как появление вспышек света, плавающих пятен или затуманенности. Если вы заметили что-то необычное, немедленно обратитесь к врачу для консультации.
СОВЕТ №3
Соблюдайте здоровый образ жизни: правильно питайтесь, занимайтесь физической активностью и избегайте вредных привычек. Это поможет поддерживать здоровье глаз и снизить риск развития заболеваний.
СОВЕТ №4
Если вам уже поставили диагноз ЗОСТ, следуйте рекомендациям врача и не пренебрегайте назначенным лечением. Это поможет сохранить зрение и предотвратить дальнейшие осложнения.